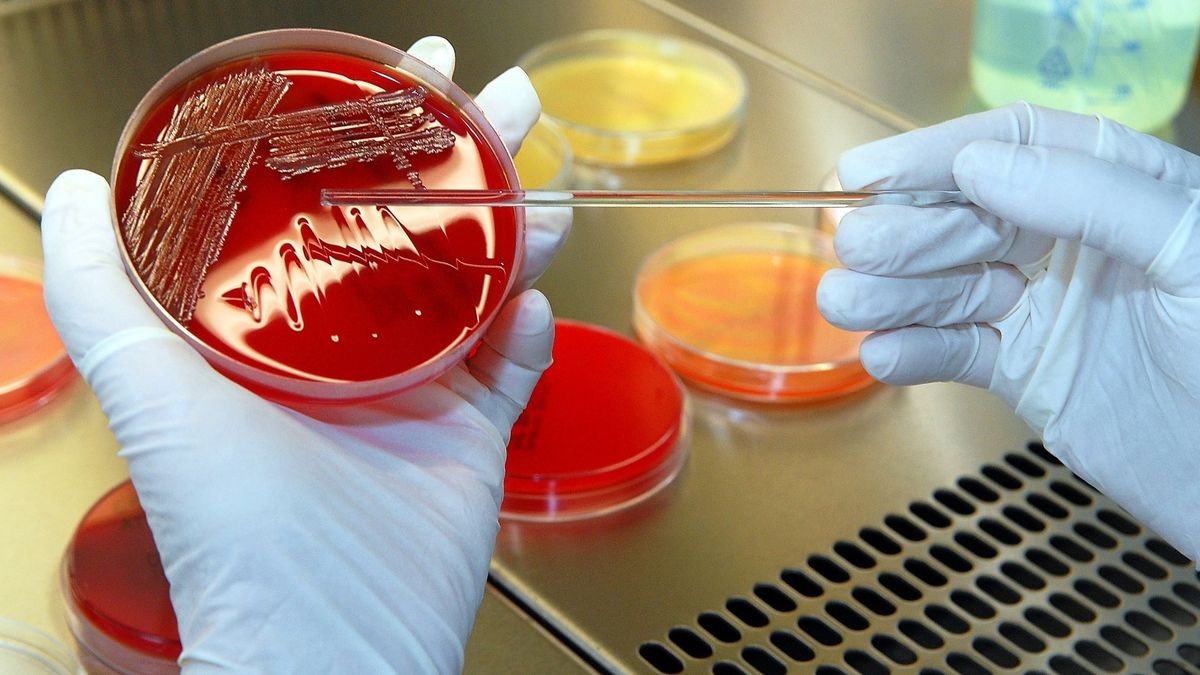

Nordhausen. Polizei und Veterinäramt ermitteln in Nordhausen. Es besteht der Anfangsverdacht einer Straftat. Nach den Untersuchungen im Landesamt liegt ein erster Befund vor.
Grauenvoller Fund
Zwölf Hundewelpen in Nordhausen einfach weggeworfen - Ergebnisse der Pathologie
•
Lesezeit: 1 Minute
Von Jens Feuerriegel
Die pathologischen Untersuchungen der toten Welpen laufen im Thüringer Landesamt für Verbraucherschutz (Symbolbild).
© Archiv | Susann Fromm